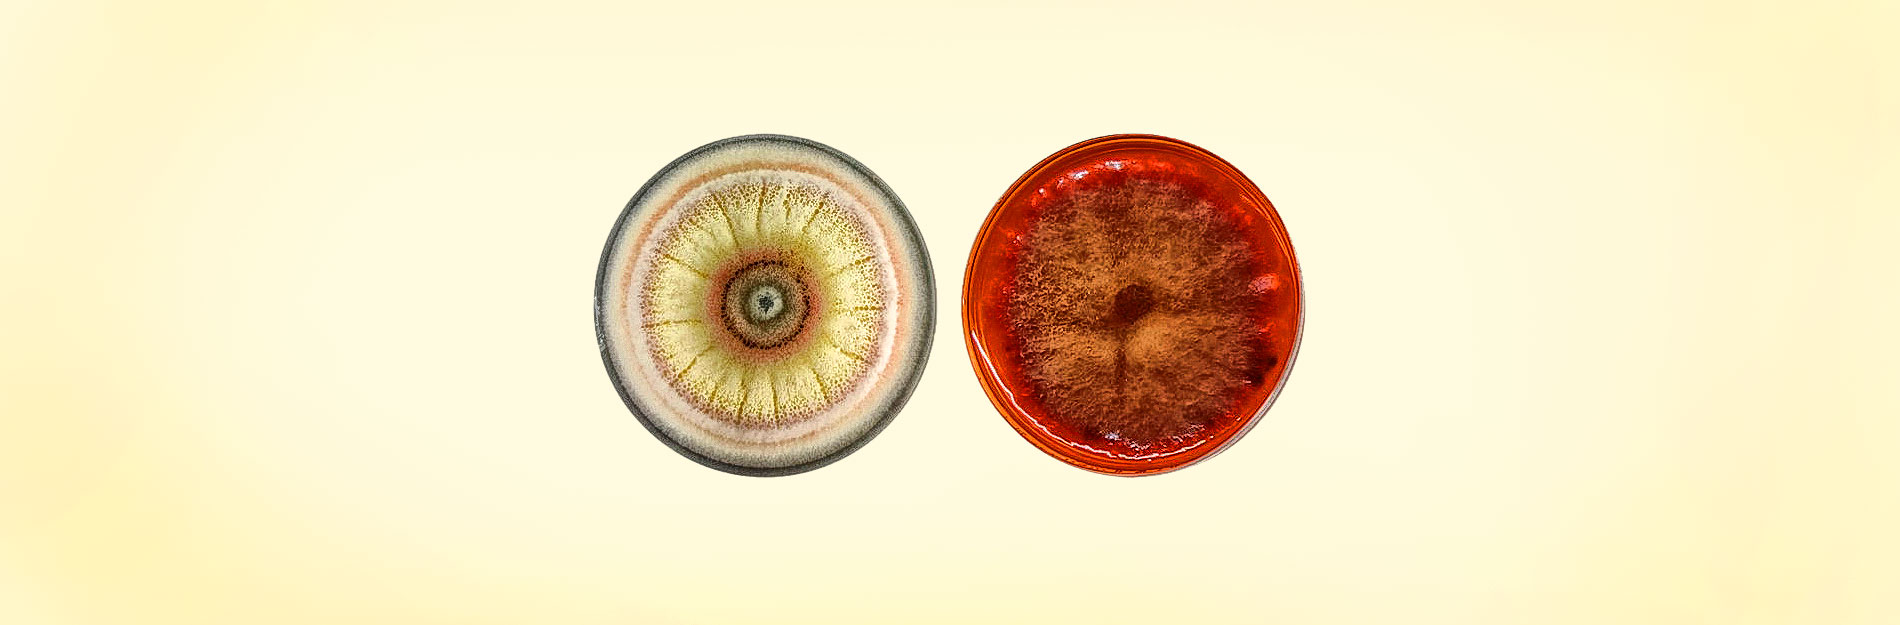

Hongos contra la resistencia bacteriana: ¿una nueva alternativa?
Mariana Irán Rodríguez Cayón, José Antonio Cervantes Chávez
Ver en el PDF
La resistencia bacteriana es el mecanismo que algunas especies de bacterias desarrollan para resistir la acción de antibióticos que provocarían su muerte. Estos mecanismos son resultado de la adaptación genética o de factores adquiridos.
Actualmente, la búsqueda de fuentes de compuestos con capacidad antimicrobiana es de interés científico y tiene el objetivo de brindar alternativas para paliar la resistencia bacteriana y evitar problemas de salud pública y agropecuaria.
En este sentido, la investigación se enfoca en el estudio de metabolitos secundarios producidos por plantas y hongos con potencial acción antimicrobiana. Los hongos Epicoccum nigrum y Monascus sanguineus producen compuestos que, se ha demostrado, poseen actividad antimicrobiana, y representan una posible alternativa a los antibióticos convencionales.
Hoy en día, la resistencia bacteriana a antibióticos causa la muerte de 5 millones de personas cada año. Según pronósticos de la Organización Mundial de la Salud, para el año 2050 esta cantidad podría aumentar a 10 millones de muertes anuales. Esta cifra es mayor que los decesos provocados por enfermedades no transmisibles, como diabetes o cáncer, por lo tanto, se destaca la importancia de apostar en proyectos de investigación y desarrollo de nuevos antibióticos producidos a partir de fuentes alternativas como los hongos.
¿CÓMO SE GENERA LA RESISTENCIA BACTERIANA?
Las bacterias resistentes, a través de mecanismos intrínsecos o adquiridos, pueden evadir el efecto de los antibióticos. Los primeros son inherentes a las bacterias debido a su estructura o sus funciones biológicas. Ejemplos de ese grupo de mecanismos son la pared celular bacteriana, que evita que el antibiótico se infiltre, y la síntesis enzimática para la degradación de compuestos con capacidad bactericida. Por otro lado, los mecanismos adquiridos son resultado de mutaciones genéticas o de la transferencia horizontal de genes a través de transposones o plásmidos; en su conjunto, brindan características que codifican para la resistencia, dado que inactivan la molécula del antibiótico, lo eliminan con facilidad del interior de la célula, o alteran la diana hacia la que van dirigidos (Jian et al., 2021).
Cuanto mayor sea la exposición y el contacto de una bacteria con dosis subletales de un antibiótico, más probable será que desarrolle algún mecanismo para evadirlo. Los grados de resistencia bacteriana han sido clasificados en tres niveles, en orden creciente según el riesgo que generan a la salud pública y agropecuaria. El primer nivel es la resistencia a más de un agente antimicrobiano, o bien, a un agente antimicrobiano clave, es decir, aquel que es considerado el antibiótico de elección para combatir la bacteria en cuestión, como sucede con cepas de Staphylococcus aureus resistentes a la meticilina, o enterococos resistentes a vancomicina.
Las bacterias que pertenecen al segundo grado son conocidas como “altamente resistentes a agentes antimicrobianos” y son resistentes a por lo menos dos antimicrobianos claves.
Por último, el grado pandrogo-resistente, hace referencia a la resistencia a todos los agentes antimicrobianos (Figura 1), aunque, en países en vías de desarrollo, este grado puede ser aplicado a organismos resistentes a todos los agentes antimicrobianos a los que se tiene acceso en dicho país (Magiorakos et al., 2012).
Por ello, resulta imprescindible la búsqueda de estrategias para mitigar el desarrollo de bacterias resistentes, y la población en general debe de ser consciente y reconocer aquellas malas prácticas que propician esta problemática.
ESTRATEGIAS DE CONTENCIÓN Y MITIGACIÓN DE RESISTENCIA
Existen medidas para reducir el desarrollo de resistencia bacteriana en distintos sectores de la población. Los profesionales de la salud tienen la responsabilidad de diagnosticar con precisión el microorganismo causante de la infección, utilizando cultivos bacterianos y pruebas de sensibilidad para prescribir el tratamiento adecuado. A su vez, la población debe seguir estrictamente el tratamiento en humanos, mascotas y otros animales. La continuidad del plan terapéutico, incluso cuando los síntomas o signos de infección hayan desaparecido, evitará la supervivencia y propagación de bacterias con potencial de desarrollar resistencia.
Además, el personal médico veterinario y zootecnista es responsable de establecer el tiempo de retiro adecuado de los antibióticos entre su administración en animales de consumo y su posterior sacrificio, reduciendo así la presencia de residuos de antibióticos en carne, leche, huevos y otros productos de origen animal destinados al consumo humano. Aunado a esto, el profesional de la salud animal debe evitar el contacto innecesario de antibióticos con bacterias ambientales, manteniendo la limpieza en corrales, campos e instalaciones, con el apoyo de los trabajadores.
Otra medida en el sector agropecuario es el uso adecuado de equipo de protección (guantes, batas, overoles, botas o tapetes sanitarios) por parte de médicos veterinarios zootecnistas y trabajadores que tengan contacto con animales enfermos. Esto tiene como objetivo prevenir la propagación de bacterias resistentes a los antibióticos que puedan causar zoonosis, es decir, infecciones que se transmiten de animales a humanos y que pueden ser difíciles de tratar.
ALTERNATIVAS CONTRA LA RESISTENCIA BACTERIANA A ANTIBIÓTICOS
Hoy en día, existen otras opciones para combatir a las bacterias resistentes a antibióticos, entre las que destacan las nanopartículas de plata u otros metales que potencian la acción de antibióticos al combinarse con ellos; sin embargo, los materiales comúnmente utilizados para su síntesis son tóxicos para animales y humanos, además de que deterioran el medio ambiente. Los bacteriófagos son virus que atacan bacterias, y representan una perspectiva interesante; no obstante, a diferencia de los antibióticos, carecen de versatilidad al ser altamente específicos, ya que en muchas ocasiones actúan únicamente contra una sola especie de bacteria.
Debido a estas desventajas, continúa la búsqueda de moléculas con actividad antimicrobiana a partir de fuentes naturales, como los metabolitos producidos por hongos, plantas o bacterias. Esta es una línea de investigación que se ha desarrollado desde que Alexander Fleming descubrió en 1928 un metabolito secundario proveniente de hongos del género Penicillium, capaz de inhibir el crecimiento de bacterias, al que hoy conocemos como penicilina, y que cambió el curso de la historia de la humanidad. Las moléculas consideradas metabolitos secundarios son resultado de diversas rutas metabólicas y se caracterizan por no estar vinculadas al crecimiento, desarrollo o reproducción del organismo, al que sin embargo aportan una ventaja; por ejemplo, la capacidad de inhibir el crecimiento de otros organismos que compiten por los mismos recursos (Abdel-Aziz et al., 2017). Se diferencian de los metabolitos primarios en función, origen y estructura química (Figura 2).
La identificación y cuantificación de estos compuestos han sido un desafío, pues son compuestos numerosos que pueden tener una o varias funciones y cuya síntesis dependerá de las condiciones particulares de crecimiento del organismo. Estos metabolitos se producen como mecanismo de defensa ante la influencia de factores externos como la radiación ultravioleta, la temperatura, las condiciones de pH, los daños físicos, la respuesta ante enfermedades, así como en respuesta a las condiciones en que el organismo crece, y suelen estar relacionados con los colores, texturas, sabores y aromas característicos de los organismos. Es por ello que algunos son usados en la industria como colorantes en textiles, alimentos, materiales, etcétera, y su uso se extiende en la actualidad a las industrias farmacéutica y agroalimentaria como antimicrobianos, antifúngicos o herbicidas, entre otros.
HONGOS FILAMENTOSOS: ¿UNA ALTERNATIVA?
Los hongos filamentosos o mohos son organismos microscópicos que pueden encontrarse en diversas fuentes como alimentos, suelos, plantas, animales, entre otros.
Su nombre se debe a que poseen estructura en forma de filamentos, generalmente microscópicos, conocidos como hifas. Durante su ciclo de vida, los hongos son capaces de producir una variedad de compuestos con funciones específicas (da Costa Souza et al., 2016).
En la naturaleza existe una gran variedad de hongos filamentosos que se han estudiado; por ejemplo, Epicoccum nigrum y Monascus sanguineus con propiedades importantes y variadas (Figura 3).
El primero está presente en diferentes tipos de suelo, alimentos, plantas e incluso pieles de animales (aunque no existe evidencia de que sea perjudicial para estos). Por su parte, M. sanguineus es utilizado desde tiempos ancestrales en países asiáticos para la fermentación de arroz y otros alimentos a los que añade una característica pigmentación rojiza (Kumar Shetty et al., 2021).
A diferencia de otros hongos de su género, su producción de toxinas es escasa o nula, por lo que su consumo no representa un riesgo.
En ambos hongos se han reportado metabolitos secundarios con actividades antibacterianas, antioxidantes, antitumorales e incluso anticancerígenas (Agboyibor et al., 2018; Dzoyem et al., 2017), y su proceso de crecimiento es relativamente sencillo en comparación con otros. Es por ello que actualmente se llevan a cabo proyectos de investigación enfocados en el estudio de metabolitos secundarios con actividad antimicrobiana, producidos por E. nigrum y M. sanguineus con la finalidad de buscar compuestos capaces de inhibir el crecimiento de bacterias resistentes.
CONCLUSIONES
Es importante apostar por las investigaciones enfocadas en el desarrollo de nuevas formas de inhibir a las bacterias patógenas. Es de igual relevancia que los organismos gubernamentales sean capaces de controlar la venta de antibióticos sin receta médica y se deben tomar medidas para concientizar a la población acerca del uso inapropiado de estos medicamentos. Hay un camino largo por recorrer, pero si se cuenta con el apoyo y la contribución de todos los sectores, se tiene por delante una gran oportunidad en la lucha contra la resistencia bacteriana.
REFERENCIAS
Abdel-Aziz SM, Abo Elsoud MM and Anise AAH (2017). Microbial Biosynthesis: A Repertory of Vital Natural Products. In Handbook of Food Bioengineering, Food Biosynthesis (pp. 25-54). Academic Press.
Agboyibor C, Kong WB, Chen D, Zhang AM and Niu SQ (2018). Monascus pigments production, composition, bioactivity and its application: A review. Biocatalysis and Agricultural Biotechnology 16:433-447.
Da Costa Souza PN, Grigoletto TLB, de Moraes LAB, Abreu LM, Guimarães LHS, Santos C, Galvão LR and Cardoso PG (2016). Production and chemical characterization of pigments in filamentous fungi. Microbiology 162:12-22.
Dzoyem JP, Melong R, Tsamo AT, Maffo T, Kapche DGWF, Ngadjui BT, McGaw LJ and Eloff JN (2017). Cytotoxicity, antioxidant and antibacterial activity of four compounds produced by an endophytic fungus Epicoccum nigrum associated with entada abyssinica. Revista Brasileira de Farmacognosia 27:251-253.
Jian Z, Zeng L, Xu T, Sun S, Yan S, Yang L, Huang Y, Jia J and Dou T (2021). Antibiotic resistance genes in bacteria: Occurrence, spread, and control. Journal of Basic Microbiology 61:1049-1070.
Kumar Shetty AV, Dave N, Murugesan G, Pai S, Pugazhendhi A, Varadavenkatesan T, Vinayagam R and Selvaraj R (2021). Production and extraction of red pigment by solid-state fermentation of broken rice using Monascus sanguineus NFCCI 2453. Biocatalysis and Agricultural Biotechnology 33(101964).
Magiorakos AP, Srinivasan A, Carey RB et al. (2012). Multidrug-resistant, extensively drug-resistant and pandrug-resistant bacteria: An international expert proposal for interim standard definitions for acquired resistance. Clinical Microbiology and Infection 18:268-281.